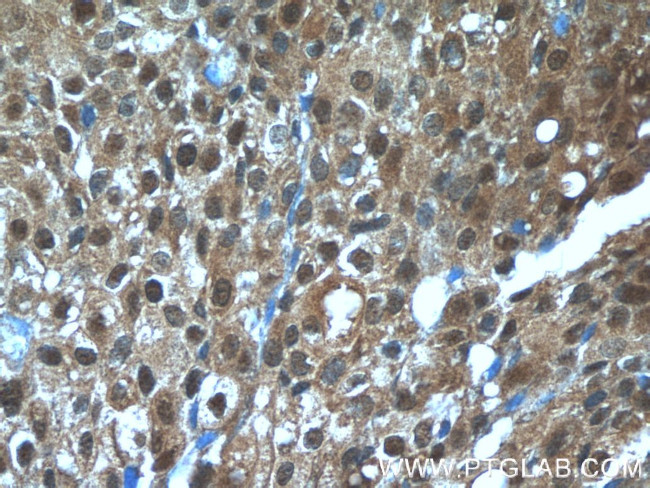
TBX18 Antibody in Immunohistochemistry (Paraffin) (IHC (P))
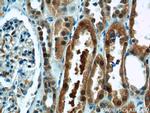
TBX18 Antibody in Immunohistochemistry (Paraffin) (IHC (P))

Search
Proteintech
TBX18 Polyclonal Antibody
{{$productOrderCtrl.translations['antibody.pdp.commerceCard.promotion.promotions']}}
{{$productOrderCtrl.translations['antibody.pdp.commerceCard.promotion.viewpromo']}}
{{$productOrderCtrl.translations['antibody.pdp.commerceCard.promotion.promocode']}}: {{promo.promoCode}} {{promo.promoTitle}} {{promo.promoDescription}}. {{$productOrderCtrl.translations['antibody.pdp.commerceCard.promotion.learnmore']}}
产品信息
23237-1-AP
种属反应
宿主/亚型
分类
类型
抗原
偶联物
形式
浓度
规格
纯化类型
保存液
内含物
保存条件
运输条件
产品详细信息
This antibody specifically reacts with the 65 kDa TBX18 protein.
Immunogen sequence: PSLRTLTFE DIPGIPKQGN ASSSTLLQGT GNGVPATHPH LLSGSSCSSP AFHLGPNTSQ LCSLAPADYS ACARSGLTLN RYSTSLAETY NRLTNQAGET FAPPRTPSYV GVSSSTSVNM SMGGTDGDTF SCPQTSLSMQ ISGMSPQLQY IMPSPSSNAF ATNQTHQGSY NTFRLHSPCA LYGY (350-532 aa encoded by B C157841)
靶标信息
The T-box (Tbx) motif is present in a family of genes whose structural features and expression patterns support their involvement in developmental gene regulation. The Tbx gene family are largely conserved throughout metazoan evolution, and these genes code for putative transcription factors that share a uniquely defining DNA-binding domain. Tbx genes are a family of developmental regulators with more than 20 members recently identified in invertebrates and vertebrates. Mutations in Tbx genes are associated with the onset of several human diseases. Our understanding of functional mechanisms of Tbx products has come mainly from the prototypical T/Brachyury, which is a transcription activator. The Tbx genes constitute a family of transcriptional regulatory genes that are implicated in a variety of developmental processes ranging from the formation of germ layers to the organizational patterning of the central nervous system.
仅用于科研。不用于诊断过程。未经明确授权不得转售。
生物信息学
蛋白别名: T-box 18; T-box protein 14; T-box protein 15; T-box protein 18; T-box transcription factor TBX18; TBX14; TBX15
基因别名: 2810012F10Rik; 2810404D13Rik; CAKUT2; PUJO; TBX18
UniProt ID: (Human) O95935, (Mouse) Q9EPZ6
Entrez Gene ID: (Human) 9096, (Rat) 315870, (Mouse) 76365